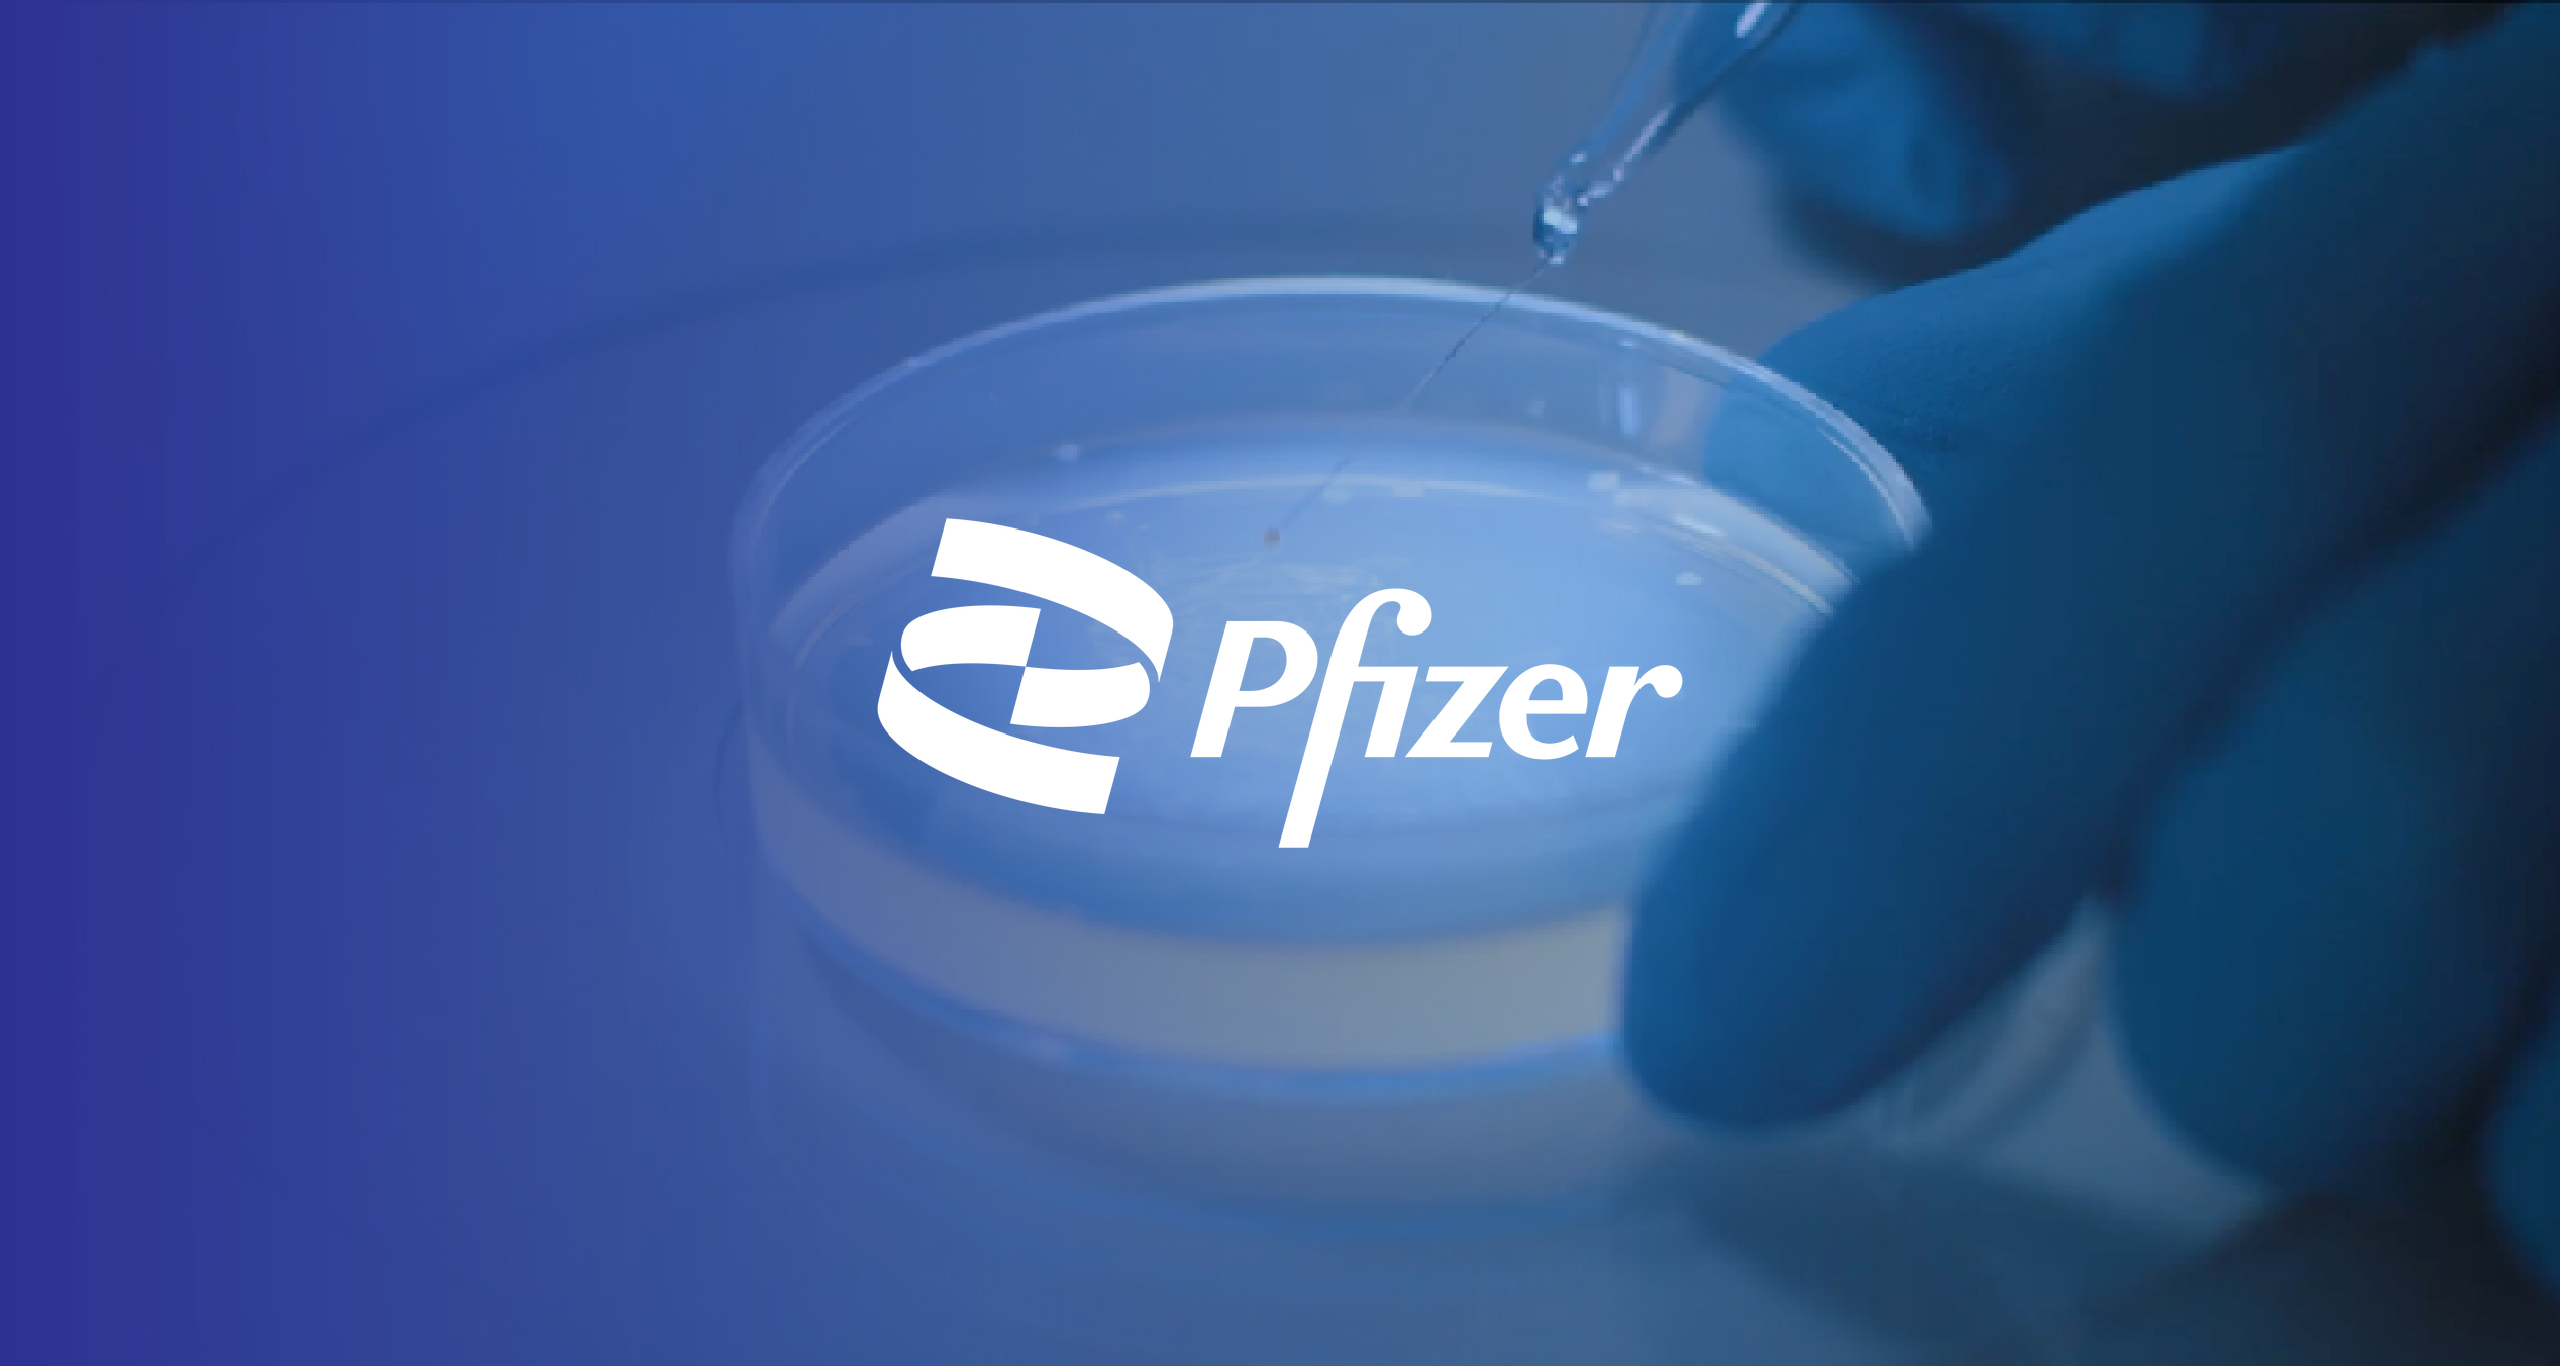
Pfizer 2

2019 Work
Whether you are launching a startup or scaling a legacy brand, we craft storytelling-led, tailor-made solutions to help you stand out, locally and globally. We also specialize in healthcare communication, delivering impactful campaigns for some of the region’s leading pharmaceutical brands.
of substance